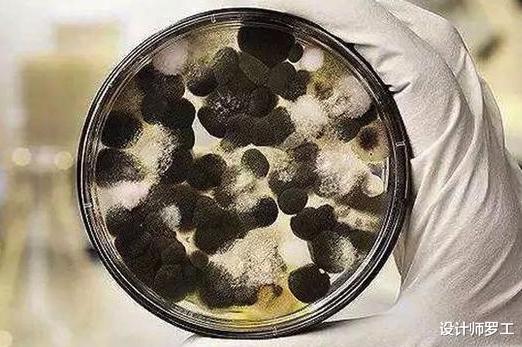

文章图片
文章图片

文章图片

文章图片

文章图片

文章图片

文章图片

文章图片

文章图片

每年雨季都会持续一段时间 , 特别是台风天气 , 雨会一直下个不停 , 空气湿度很高 , 在室内会非常潮湿 。
对于潮湿天气 , 就不得不说南方的“回南天”了 , 那种潮湿 , 只有经历过 , 才知道有多恐怖 。 衣服会越晾越湿 , 墙砖、玻璃、金属材质表面都会布满水珠 , 连床铺都是湿的 。
如果家里长期处于这样潮湿的环境 , 很容易就有出现发霉 , 让人十分头疼 。
本期分享:每年雨季一到 , 家里“到处发霉”?教你2招 , 霉斑自动消失!
发霉的危害墙体发霉或者食物发霉 , 会产生霉菌 , 它是一种对人体危害性大的毒素 。
它的繁殖能力强 , 如果出现霉菌不及时去除 , 任由它发展 , 会对人体产生伤害 , 轻则会引起过敏、免疫力降低 , 严重的话会中毒、致癌等 。
为什么会发霉?发霉最根本的原因就是水分 , 只有水分才会产生这现象 。 如果是一个干爽的空间 , 一般都不会发霉 。
那有朋友可能会问?我家的墙面没有水啊 , 怎么会发霉呢?
其实这些水分是肉眼看不到而已 , 它们来自于潮湿空气中 , 室内外温差过大和暗藏在墙体内的水管渗漏等等 。
那些位置容易发霉?家中的那些位置容易出现发霉现象呢?通常都有这几处地方:
①、卫生间墙体的另一侧
卫生间是家里最潮湿的空间 , 也是暗藏水管最多的地方 。
卫生间的墙体另一侧一般是卧室或客餐厅的墙体 , 而这些位置的墙体是发霉“大户” 。
原因有以下两点:
A、水管出现渗漏
给水管是暗藏在墙体内 , 而卫生间又是水管最多的地方 。 如果在装修过程中 , 例如:安装洗手台时要钻孔 , 不小心钻穿水管;水龙头和花洒与水管接口的生胶带老化 。
这此情况都会导致渗漏 , 而渗漏的水会很少 , 比较难发现 , 水分长期积在墙体内 , 慢慢地就开始发霉了 。
B、防水做得不好
卫生间的墙体虽然都做了防水 , 但由于防水做得不好或者防水只刷到1.8米高 , 那么水分会透过砖缝、吊顶或沉池等地方渗到墙体 , 久而久之就发霉 。
- 高考满分作文精选 优秀高考满分作文欣赏
- 2021年梅雨时间 梅雨季节是什么时间2021年
- 每年春节能不能固定在某一天呢?
- 一到冬天就脚冷,有什么适合冬天穿的鞋子推荐吗?
- 荔枝吃了有啥好处 吃荔枝好处?
- 每年支付宝什么时候扫福字 支付宝扫福一天可以扫几个
- 刚入行审计,目前有一到两个月空闲期,应该如何规划日常的充电学习?
- 一到了过年农村家家户户都贴春联,不贴春联可以吗?
- nba篮球经理手游 nba篮球经理2020
- 2021高考是每年的几月几号 2021高考时间是几月几号一
特别声明:本站内容均来自网友提供或互联网,仅供参考,请勿用于商业和其他非法用途。如果侵犯了您的权益请与我们联系,我们将在24小时内删除。
